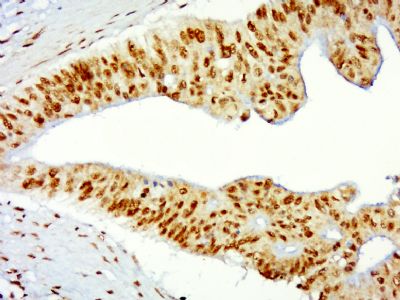
Histone H3/HIST3H3 antibody

相关产品推荐更多 >
万千商家帮你免费找货
0 人在求购买到急需产品
- 详细信息
- 文献和实验
- 技术资料
- 供应商:
上海康朗生物科技有限公司
- 库存:
大量
- 目录编号:
kl-0349R
- 克隆性:
多克隆
- 抗原来源:
Rabbit
- 保质期:
12个月
- 抗体英文名:
Histone H3/HIST3H3 antibody
- 抗体名:
组蛋白H3抗体
- 宿主:
Rabbit
- 适应物种:
Human, Mouse, Rat, Pig, Cow, Rabbit, Fruit Fly,
- 免疫原:
KLH conjugated synthetic peptide derived from human Histone H3:71-136/136
- 亚型:
IgG
- 形态:
冻干粉或液体
- 应用范围:
WB=1:500-2000 ELISA=1:500-1000 IHC-P=1:400-800 IHC-F=1:400-800 Flow-Cyt=1μg/Test ICC=1:100-500 IF=1:100-500
- 浓度:
1mg/ml
- 保存条件:
-20 °C
- 规格:
50ul 100ul 200ul
| 中文名称 | 组蛋白H3抗体 |
| 别 名 | H3 histone family member E pseudogene; H3F3; HIST3H3; Histone H3 3 pseudogene; H31_TETTH; Histone H3; H3S; Histone H3-I/H3-II; Major histone H3; H3F; Histone H3/a; Histone H3/b; Histone H3/c; Histone H3/d; Histone H3/f; Histone H3/h; Histone H3/i; Histone H3/j; Histone H3/k; Histone H3/l. |
![]() |
Specific References (9) | bs-0349R has been referenced in 9 publications. [IF=2.97] Liu, Donghui, et al. ʺNonenzymatic glycation of high‐density lipoprotein impairs its anti‐inflammatory effects in innate immunity.ʺ Diabetes/Metabolism Research and Reviews 28.2 (2012): 186-195. WB ; Human. PubMed:21928330 [IF=1.31] Wang, Chunqiang, Wei Ma, and Yuhong Su. ʺNF-κB Pathway Contributes to Cadmium-Induced Apoptosis of Porcine Granulosa Cells.ʺ Biological trace element research (2013): 1-8. WB ; Pig. PubMed:23575899 [IF=4.75] Duan, Chao, et al. "Oestrogen receptor‐mediated expression of Olfactomedin 4 regulates the progression of endometrial adenocarcinoma." Journal of Cellular and Molecular Medicine (2014). WB ; Human. PubMed:24495253 [IF=1.52] Tang, Z-X., et al. "Selective antegrade cerebral perfusion attenuating the TLR4/NF-κB pathway during deep hypothermia circulatory arrest in a pig model." Cardiology 128.3 (2014): 243-250. WB ; Pig. PubMed:24819356 [IF=8.56] Qian, Yi, et al. "Silver Nanoparticle-Induced Hemoglobin Decrease Involves Alteration of Histone 3 Methylation Status." Biomaterials (2015). WB ; Mouse. PubMed:26295435 [IF=1.88] Zhao, Hongyu, et al. "Glycyrrhizic Acid Attenuates Sepsis-Induced Acute Kidney Injury by Inhibiting NF-κB Signaling Pathway." Evidence-Based Complementary and Alternative Medicine (2015). WB ; Rat. PubMed:not posted yet [IF=2.68] Shen, Haitao, et al. "Epigallocatechin-3-gallate alleviates paraquat-induced acute lung injury and inhibits upregulation of toll-like receptors." Life Sciences (2016). WB ; Mouse. PubMed:27890776 [IF=3.91] Dong, Wei-tao, et al. "iTRAQ proteomic analysis of the interactions between Bombyx mori nuclear polyhedrosis virus and silkworm." Journal of Proteomics (2017). WB ; Other Species. PubMed:0 [IF=4.12] Joy, Marion, et al. "The Myocardin-related transcription factor MKL co-regulates the cellular levels of two profilin isoforms." Journal of Biological Chemistry (2017): jbc-M117. WB ; Human. PubMed:28546428 |
| 规格价格 | 50ul/780元 购买 100ul/1380元 购买 200ul/2200元 购买 大包装/询价 |
| 说 明 书 | 50ul 100ul 200ul |
| 研究领域 | 免疫学 细胞周期蛋白 |
| 抗体来源 | Rabbit |
| 克隆类型 | Polyclonal |
| 交叉反应 | Human, Mouse, Rat, Pig, Cow, Rabbit, Fruit Fly, |
| 产品应用 | WB=1:500-2000 ELISA=1:500-1000 IHC-P=1:400-800 IHC-F=1:400-800 Flow-Cyt=1μg/Test ICC=1:100-500 IF=1:100-500 (石蜡切片需做抗原修复) not yet tested in other applications. optimal dilutions/concentrations should be determined by the end user. |
| 分 子 量 | 15kDa |
| 细胞定位 | 细胞核 |
| 性 状 | Lyophilized or Liquid |
| 浓 度 | 1mg/ml |
| 免 疫 原 | KLH conjugated synthetic peptide derived from human Histone H3:71-136/136 |
| 亚 型 | IgG |
| 纯化方法 | affinity purified by Protein A |
| 储 存 液 | 0.01M TBS(pH7.4) with 1% BSA, 0.03% Proclin300 and 50% Glycerol. |
| 保存条件 | Store at -20 °C for one year. Avoid repeated freeze/thaw cycles. The lyophilized antibody is stable at room temperature for at least one month and for greater than a year when kept at -20°C. When reconstituted in sterile pH 7.4 0.01M PBS or diluent of antibody the antibody is stable for at least two weeks at 2-4 °C. |
| PubMed | PubMed |
| 产品介绍 | background: Modulation of the chromatin structure plays an important role in the regulation of transcription in eukaryotes. The nucleosome, made up of four core histone proteins (H2A, H2B, H3 and H4), is the primary building block of chromatin. The N-terminal tail of core histones undergoes different posttranslational modifications including acetylation, phosphorylation and methylation. These modifications occur in response to cell signal stimuli and have a direct effect on gene expression. In most species, the histone H2B is primarily acetylated at lysines 5, 12, 15 and 20. Histone H3 is primarily acetylated at lysines 9, 14, 18 and 23. Acetylation at lysine 9 appears to have a dominant role in histone deposition and chromatin assembly in some organisms. Phosphorylation at Ser10 of histone H3 is tightly correlated with chromosome condensation during both mitosis and meiosis. Function: Core component of nucleosome. Nucleosomes wrap and compact DNA into chromatin, limiting DNA accessibility to the cellular machineries which require DNA as a template. Histones thereby play a central role in transcription regulation, DNA repair, DNA replication and chromosomal stability. DNA accessibility is regulated via a complex set of post-translational modifications of histones, also called histone code, and nucleosome remodeling. H3 is deposited into chromatin exclusively through a DNA replication-coupled pathway that can be associated with either DNA duplication or DNA repair synthesis during meiotic homologous recombination. Subunit: The nucleosome is a histone octamer containing two molecules each of H2A, H2B, H3 and H4 assembled in one H3-H4 heterotetramer and two H2A-H2B heterodimers. The octamer wraps approximately 147 bp of DNA. Interacts with GCN5, whereby H3S10ph increases histone-protein interactions. Interacts with PDD1 and PDD3. Subcellular Location: Nucleus. Chromosome. Note=Localizes to both the large, transcriptionally active, somatic macronucleus (MAC) and the small, transcriptionally inert, germ line micronucleus (MIC). Post-translational modifications: Phosphorylated to form H3S10ph. H3S10ph promotes subsequent H3K14ac formation by GCN5. H3S10ph is only found in the mitotically dividing MIC, but not in the amitotically dividing MAC. H3S10ph is correlated with chromosome condensation during mitotic or meiotic micronuclear divisions. Acetylation of histone H3 leads to transcriptional activation. H3K14ac formation by GCN5 is promoted by H3S10ph. H3K9acK14ac is the preferred acetylated form of newly synthesized H3. Acetylation occurs almost exclusively in the MAC. Methylated to form H3K4me. H3K4me is only found in the transcriptionally active MAC. Methylated to form H3K9me in developing MACs during conjugation, when genome-wide DNA elimination occurs. At this stage, H3K9me specifically occurs on DNA sequences being eliminated (IES), probably targeted by small scan RNAs (scnRNAs) bound to IES, and is required for efficient IES elimination. H3K9me is required for the interaction with the chromodomains of PDD1 and PDD3. The full-length protein H3S (slow migrating) is converted to H3F (fast migrating) by proteolytic removal of the first 6 residues. H3F is unique to MIC, and processing seems to occur regularly each generation at a specific point in the cell cycle. Similarity: Belongs to the histone H3 family. SWISS: P84243 Gene ID: 8290 Database links: Entrez Gene: 326601 Cow Entrez Gene: 8350 Human Entrez Gene: 8351 Human Entrez Gene: 8352 Human Entrez Gene: 8353 Human Entrez Gene: 8354 Human Entrez Gene: 8355 Human Entrez Gene: 8290 Human
Entrez Gene: 8350 Human
Entrez Gene: 8351 Human
Entrez Gene: 8352 Human
Entrez Gene: 8353 Human
Entrez Gene: 8354 Human
Entrez Gene: 8355 Human
Entrez Gene: 8356 Human
Entrez Gene: 8357 Human
Entrez Gene: 8358 Human
Entrez Gene: 8968 Human
Entrez Gene: 260423 Mouse
Entrez Gene: 319148 Mouse
Entrez Gene: 319149 Mouse
Entrez Gene: 319150 Mouse
Entrez Gene: 319151 Mouse
Entrez Gene: 319152 Mouse
Entrez Gene: 319153 Mouse
Entrez Gene: 360198 Mouse
Entrez Gene: 97908 Mouse
Entrez Gene: 100364501 Rat
Entrez Gene: 100365669 Rat
Entrez Gene: 291159 Rat
Entrez Gene: 314977 Rat
Entrez Gene: 364716 Rat
Entrez Gene: 679950 Rat
Entrez Gene: 679994 Rat
Entrez Gene: 680511 Rat
Entrez Gene: 680599 Rat
Entrez Gene: 682330 Rat
Entrez Gene: 691496 Rat
Omim: 601128 Human
Omim: 602810 Human
Omim: 602811 Human
Omim: 602812 Human
Omim: 602813 Human
Omim: 602814 Human
Omim: 602815 Human
Omim: 602816 Human
Omim: 602817 Human
Omim: 602818 Human
Omim: 602819 Human
SwissProt: P68431 Human
SwissProt: P84243 Human
SwissProt: Q16695 Human
SwissProt: Q6NXT2 Human
SwissProt: Q71DI3 Human
SwissProt: P68433 Mouse
SwissProt: P84228 Mouse
SwissProt: Q6LED0 Rat
Unigene: 132854 Human
Unigene: 247813 Human
Unigene: 247814 Human
Unigene: 248176 Human
Unigene: 443021 Human
Unigene: 484990 Human
Unigene: 532144 Human
Unigene: 533292 Human
Unigene: 546315 Human
Unigene: 586261 Human
Unigene: 591778 Human
Unigene: 221301 Mouse
Unigene: 261657 Mouse
Unigene: 377874 Mouse
Unigene: 390558 Mouse
Unigene: 397328 Mouse
Unigene: 138090 Rat
Important Note: This product as supplied is intended for research use only, not for use in human, therapeutic or diagnostic applications. 组蛋白的基因非常保守,在亲缘关系较远的种属中,四种组蛋白(H2A、H2A、H3、H4)氨基酸序列都非常相似,如海胆组织H3的氨基酸序列与来自小牛胸腺的H3的氨基酸序列间只有一个氨基酸的差异,小牛胸腺的H3的氨基酸序列与豌豆的H3也很相似。组蛋白是细胞核内的一种碱性核蛋白,抗组蛋白抗体即是以组蛋白为靶抗原的一种自身,是抗核抗体的一种。分子量:16-18KDa。主要与药物性红斑狼疮、系统性红斑狼疮、类风湿关节炎有关。 |
| 产品图片 | ![]() Sample: K562 Cell Lysate at 40 ug Primary: Anti-Histone H3/HIST3H3(bs-0349R) at 1/300 dilution Secondary: IRDye800CW Goat Anti-Rabbit IgG at 1/10000 dilution Predicted band size: 15kD Observed band size: 17kD ![]() Sample: K562(Human) Cell Lysate at 30 ug Primary: Anti-Histone H3/HIST3H3 (bs-0349R) at 1/300 dilution Secondary: IRDye800CW Goat Anti-Rabbit IgG at 1/20000 dilution Predicted band size: 15 kD Observed band size: 17 kD ![]() Paraformaldehyde-fixed, paraffin embedded (human cervical carcinoma); Antigen retrieval by boiling in sodium citrate buffer (pH6.0) for 15min; Block endogenous peroxidase by 3% hydrogen peroxide for 20 minutes; Blocking buffer (normal goat serum) at 37°C for 30min; Antibody incubation with (HIST3H3) Polyclonal Antibody, Unconjugated (bs-0349R) at 1:400 overnight at 4°C, followed by a conjugated secondary (sp-0023) for 20 minutes and DAB staining. ![]() Paraformaldehyde-fixed, paraffin embedded (human colon cancer); Antigen retrieval by boiling in sodium citrate buffer (pH6.0) for 15min; Block endogenous peroxidase by 3% hydrogen peroxide for 20 minutes; Blocking buffer (normal goat serum) at 37°C for 30min; Antibody incubation with (HIST3H3) Polyclonal Antibody, Unconjugated (bs-0349R) at 1:400 overnight at 4°C, followed by a conjugated secondary (sp-0023) for 20 minutes and DAB staining. ![]() Paraformaldehyde-fixed, paraffin embedded (Mouse stomach); Antigen retrieval by boiling in sodium citrate buffer (pH6.0) for 15min; Block endogenous peroxidase by 3% hydrogen peroxide for 20 minutes; Blocking buffer (normal goat serum) at 37°C for 30min; Antibody incubation with (Histone H3) Polyclonal Antibody, Unconjugated (bs-0349R) at 1:400 overnight at 4°C, followed by operating according to SP Kit(Rabbit) (sp-0023) instructionsand DAB staining. ![]() Tissue/cell: rat brain tissue;4% Paraformaldehyde-fixed and paraffin-embedded; Antigen retrieval: citrate buffer ( 0.01M, pH 6.0 ), Boiling bathing for 15min; Blocking buffer (normal goat serum,C-0005) at 37℃ for 20 min; Incubation: Anti-Histone H3 Polyclonal Antibody, FITC conjugated (bs-0349R-FITC) used at 1:100 dilution for 40 minutes at 37癈. ![]() Blank control: Mouse spleen cells (blue). Primary Antibody:Rabbit Anti-Histone H3/HIST3H3 antibody(bs-0349R), Dilution: 1μg in 100 μL 1X PBS containing 0.5% BSA; Isotype Control Antibody: Rabbit IgG(orange) ,used under the same conditions ); Secondary Antibody: Goat anti-rabbit IgG-PE(white blue), Dilution: 1:200 in 1 X PBS containing 0.5% BSA. Protocol The cells were fixed with 2% paraformaldehyde (10 min). Primary antibody (bs-0349R, 1μg /1x10^6 cells) were incubated for 30 min on the ice, followed by 1 X PBS containing 0.5% BSA + 1 0% goat serum (15 min) to block non-specific protein-protein interactions. Then the Goat Anti-rabbit IgG/PE antibody was added into the blocking buffer mentioned above to react with the primary antibody at 1/200 dilution for 30 min on ice. Acquisition of 20,000 events was performed. |
风险提示:丁香通仅作为第三方平台,为商家信息发布提供平台空间。用户咨询产品时请注意保护个人信息及财产安全,合理判断,谨慎选购商品,商家和用户对交易行为负责。对于医疗器械类产品,请先查证核实企业经营资质和医疗器械产品注册证情况。
文献和实验in detail here. The first protocol is essentially a dual-pulldown assay employing Flag-tagged DNMT3A or antibody of choice for an endogenous protein and 5' biotin linked antisense RNA (Figure 1a), while the second protocol is a triple pulldown assay which essentially expands
PROTOCOL To 1.5 mL eppendorf tubes add: 200 µg of protein extract (see Western blot protocol for protein sample preps) q.s. to 300 µL with RIPA (with protease and phosphatase inhibitors). Primary antibody (amount determined
Competing Chromosomal Proteins from Drosophila Polytene Chromosomes Using Modified Histone Peptides
to chromatin, by its histone tail interaction or by other interactions, then you would not expect to see loss of binding upon peptide competition. A good positive control for the assay is to use H3K9 dimethylated peptide to compete HP1 from the pericentric
技术资料暂无技术资料 索取技术资料